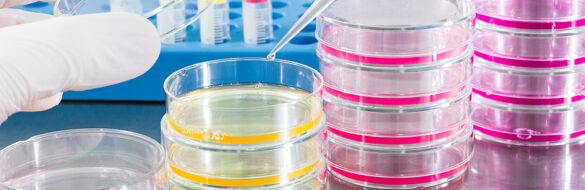

Featured
[IS] Opinions
Ex-Offenders Perform the Same or Better Than Other Employees
By
Mitch Pearlstein on October 31, 2025
America needs more workers at a time when more Americans — especially ex-offenders — need to work. How can the…
Read More
All Articles
Equipping the Next Generation With Confidence for Civic Engagement
October has offered a unique opportunity to pause and reflect on the challenges and possibilities facing our young people. Earlier…
by Diane Tomb | October 27, 2025 Read More
National Drug Take Back Day; DMV Residents Should Participate
On Oct. 25, individuals across the DMV will once again have the chance to participate in National Prescription Drug Take…
by Irina Butler | October 24, 2025 Read More
Kids’ Card Trading Isn’t Gambling, It’s ‘Growing Up’
Folks, our kids are in trouble! Trouble with a capital "T," and that stands for ... trading cards? Every decade…
by Michael Graham | October 24, 2025 Read More
When ‘Competitive Bidding’ Becomes Anti-Competition
The Centers for Medicare & Medicaid Services says its “Competitive Bidding Program” for medical equipment is designed to save taxpayers…
by Gerard Scimeca | October 24, 2025 Read More
Without Meaningful Rights, Survivors Are Just Symbols
For decades, lawmakers have invoked survivors to justify tougher laws and harsher sentences. When it comes to giving victims real…
by Bridgette Stumpf | October 24, 2025 Read More
BROUGHT TO YOU BY
FDA Must Keep Up With Science on Cancer
One or two nights a week, I get a call from an unknown number. On the other end is a…
by Garo Armen | October 24, 2025 Read More
HOLY COW! HISTORY: Hollywood Calls the Hereafter
The spookiest time of the year is upon us once more as our attention turns to jack-o’-lanterns, black cats, and…
by J. Mark Powell | October 24, 2025 Read More
Bipartisan Scrutiny Grows Over Nonprofit Hospitals’ Billions in Tax Benefits
How do you get conservative anti-DEI activist Dr. Stanley Goldfarb and New York's socialist mayor candidate Zohran Mamdani on the…
by Jessica R. Towhey | October 23, 2025 Read More